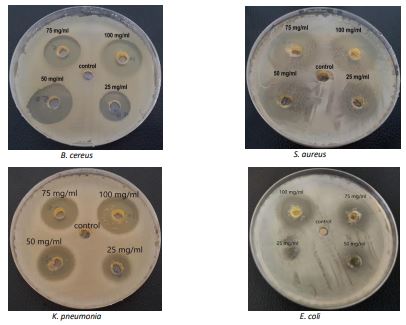

BibTeX | RIS | EndNote | Medlars | ProCite | Reference Manager | RefWorks
Send citation to:
URL: http://ijmm.ir/article-1-2559-en.html
2- Department of Pharmaceutical Chemistry, College of Pharmacy, University of Basrah, Basrah, Iraq
3- Microbiology Department, College of Veterinary Medicine, University of Basrah, Basrah, Iraq ,
One of the main issues facing the world today is drug resistance, and one of the most intriguing research topics nowadays is the need to create new molecules to address this issue. One of the most significant and well-known heterocyclic nuclei with a variety of biological activity is the thiadiazole nucleus (1). Schiff-base compounds are commonly used as antibiotics due to their chelating properties (2). Schiff-bases are considered effective chemical materials that are used in the medical field. It has been found that these compounds possess diverse biological impacts, such as antifungal (3), antibacterial (4), and anti-inflammatory (5). Schiff-bases are used as molecular parts in preparing antimicrobial drugs (6-9).
The presence of a halogen atom enhances the lipophilicity of a given molecule and makes it easier for the molecule to partition across membranes to interact hydrophobically with specific receptor or enzyme binding sites (10). Microwave-assisted synthesis can also be considered as one of the most important pillars of green chemistry (11-14). In the conditions of free or low-solvent, microwave reactions stand out by their low cost, high output, and ease of processing and manipulation.
The presence of a =N-C-S- moiety and the ring high aromaticity, which provide minimal toxicity and excellent in vivo stability, are two assumptions that underpin the biological activities of 1,3,4-thiadiazole derivatives (1).
Multidrug resistance occurrence among microorganisms encourages researchers to synthesize new compounds to control the resistant organisms. Synthesis or discovery of new compounds with effectiveness against resistant microbes is the project task.
The present work was planned with the objective of synthesizing a new compound showing antimicrobial activity. MMT was used to study the relationship between Schiff-base and antitumor action that should offer theoretical support to the subsequent search for new Schiff-base with higher efficiency, lower toxicity, and higher selectivity in the anticancer activity. As found out, the synthesized compound exhibited good anticancer activity against prostate tumor cells.
2.1 Synthesis of the novel phenol compound
The microwave approach was used to create a compound (15). Using microwave oven (Panasonic / Korea), 0.55 gr/0.004 M of 4-hydroxybenzaldehyde and 1.19 gr/0.004 M of 4-(5-amino-1,3,4-thiadiazole-2-yl) phenol were mixed with distilled water (1 ml) in a conical flask, according to previous study (16). The mixture was microwaved at 180 watts for 2 to 3 min, the reaction was observed using TLC. It was cooled at room temperature, and yellow crystals were produced upon recrystallization from ethanol. Necessary precautions such as wearing mask and gloves were taken. The structure of the compound is shown in Figure 4.
2.2 Methods of identification
First, melting point of the resulting material was stated at 112–116oC. The measurement was conducted using uncorrected digital SMP31 melting point device (Gallenkamp, UK). Then, KBr disc was used to capture FT-IR spectra using a Shimadzu FT-IR-8400 photometer (Figure 1).

Figure 1. FT-IR of the novel phenol compound
Eastman chromatography sheet (Germany) was used for TLC of starting materials and products using methyl alcohol: ethyl acetate (3:7) as eluent. UV light was used to capture the spot.
Carbon, hydrogen, nitrogen, and Sulphur were micro-analyzed by Euro vector EA 3000A Elemental analysis (Italy).
Using BRUCKER ultra shield spectrophotometer at 500 and 125 MHz, 1H-NMR (Figure 2) and 13C-NMR (Figure 3) spectra of produced substances were recorded.

Figure 2. 1H-NMR spectrum for the phenol compound in DMSO-d6 (500MHz).

Figure 3. 13C-NMR spectrum for phenol compound in DMSO-d6 (125MHz).
2.3 Pharmacology of the synthesized compound
Four bacterial isolates including 2 Gram-positive; Bacillus cereus (B. cereus) (MG711894.1) and Staphylococcus aureus (S. aureus), and 2 Gram-negative; Escherichia coli (E. coli), and Klebsiella pneumonia (K. pneumonia) were selected. The bacteria were cultured on Mannitol egg Yolk polymyxin agar, Manitol salt agar, Eosin methylene blue, and MacConkey agar, respectively. After that the cultures turbidity was adjusted to 0.5 McFarland standard (16-19).
The reasons for selecting these bacteria were as follows: B. cereus is a spore-forming bacterium that resists unsuitable environments, while S. aureus, with its ability to produce biofilm, resists many types of antibiotics. Both of these bacteria are Gram-positive, while E. coli and K. pneumonia, as Gram-negative bacteria, are responsible for many types of infections. Many antibiotics have shown high resistance in recent years (17).
The phenol compound was tested in various concentrations (100, 75, 50, 25 mg/ml) (16, 19, 20). The antibacterial sensitivity was investigated on Muller Hinton Agar in well diffusion technique (19, 21). The MIC values were determined using well diffusion method on four bacterial strains at quantities previously mentioned. Different concentrations of the synthesized compound were dissolved in DMSO. The McFarland standard for bacterial suspensions was set at 0.5 (1.5*108) CFU (16, 19, 22).
The anticancer activity of the phenol compound was assessed using an MTT assay against prostate cancer cells (CRL-1740 from lymph node metastasis of a human prostate adenocarcinoma). Cells were cultured in Dulbecco's Modified Eagle Medium (DMEM) with 10% fetal bovine serum (FBS). The cells were seeded in 96-well plate (104 cells/well) for 24 hr to reach 80% confluency and then exposed to different concentrations of compound (duplicate/each) for 24, 48, and 72 hr at 37°C, 5% CO2. Cells not exposed to the compound were considered as control. Following incubation times, the plate was exposed to 1X MTT (100µl/well) for 3-4 hr at 37°C, 5% CO2 in dark. Then, formazan crystals were dissolved with DMSO (100µl/well). The cell viability was calculated using an ELISA reader (BIOTEK 800TS/Denmark) at 540 nm absorbance measurement (23-25). DMSO was tested in parallel as solvent control.
2.4 Statistical analysis
Data were analyzed by SPSS version 18.0, using One-way ANOVA, Tukey post-hoc test. P value less than 0.05 was considered as significant.
3.1 Characteristics of Novel Synthesized Compound
The synthesized Schiff-base compound was analyzed using FT-IR and NMR that both gave good indications, which confirmed the structure of the prepared compound shown in Figure 4.
Figure 4. Structure of 4-{5-((4-hydroxybenzylidene) amino)-1,3,4-thiadiazol-2-yl) phenol}
Elemental analysis; Calculated (Found) = C: 60.59 (60.49), H: 3.73 (3.56), N: 14.13 (14.35), S: 10.78(10.46). FT-IR spectrum for the prepared substance by KBr disc: טOH 3215 cm-1, טC-Harom.3047cm-1, ʋC=N1668cm-1, טOHbending1598cm-1, ʋC= Casym.1516cm-1, ʋC=Csym. 1454 cm-1, ט C-N 1315 cm-1, ʋN-N= 1286 cm-1, טC-S= 702 cm-1 (see Figure 1).
DMSO-d6 was used as the solvent (500MHz) via 1H-NMR spectrum to test the new material. To sum up, the spectrum showed a signal at 6.95 ppm (d) that could be from 4H (C9, C13, and C9', C13'), (J=8.75Hz); a signal at 7.77 ppm(d) that could be from 4H (C10, C12, and C10', C12'); a signal at 9.79 ppm(s) that could be from a proton of (C7); and a broad signal at 10.65 ppm (s) that could be from 2H (OH), or (C11, C11') (see Figure 2).
A 125 MHz DMSO-d6 solution was used to record the 13C-NMR spectrum of the manufactured chemical. The bands that were recorded were 116.31 ppm for C10, C12, C10', and C12', 128.87 ppm for C8, C8', C9', and C13', 132.58 ppm for C9 and C13, 163.82 ppm for C7, C11, and C11', 173.12 ppm for C2, and 191.44 ppm for C5 (see Figure 3).
3.2 Antibacterial efficacy of the compound
The antibacterial efficacy of the compound was illustrated in Table 1 and Figure 5.
Table 1. Antibacterial activity of the compound
| Inhibition zone (mm) | Bacteria / conc. | |||
| 25 mg/ml | 50 mg/ml | 75 mg/ml | 100 mg/ml | |
| 18 | 22 | 23 | 26 | B. cereus |
| 18 | 26 | 29 | 31 | S. aureus |
| 26 | 27 | 28 | 33 | E. coli |
| 17 | 18 | 20 | 25 | K. pneumonia |
Figure 5. Antibacterial activity of the compound on Muller Hinton Agar.
Table 2. MIC values of novel phenol compound
| Conc. mg/mL | Diameter of the inhibition zone (mm) | |||
| B. cereus | S. aureus | E. coli | K. pneumoniae | |
| 15 | 18 | 15 | 12 | 17 |
| 10 | 15 | 14 | 10 | 14 |
| 5 | 14 | 12 | 5 | 13 |
| 3 | 13 | 8 | 0 | 12 |
| 1 | 5 | 0 | 0 | 11 |
| 0.8 | 0 | 0 | 0 | 0 |
| 0.7 | 0 | 0 | 0 | 0 |
Figure 6. Antibacterial activity at different concentrations of phenol compound
3.4 Anticancer Activity
The product effectiveness in inhibiting prostate cancer cell (CRL-1740) growth was demonstrated using 0.03 μg/ml concentration in duplicate as shown in MTT cell viability assay. No significant difference was observed between attempts 1 and 2 with control at 24 – 48 hr, but there was significant difference at 72 hr (chi-square = 6.180; P<0.05). The results are shown in Figures 7, 8.

Figure 7. The chart shows CRL-1740 cell viabilities in exposure to phenol compound 0.03 μg/ml concentration at 24, 48, and 72 hr exposure.
Figure 8. A) Untreated CRL-1740 cells as control; B) CRL-1740 adenocarcinoma treated with the compound.
We synthesized a new compound using the microwave method by mixing equal amounts (0.004 M) of 4-hydroxybenzaldehyde and 4-[5-{4-hydroxybenzylidne} amino)-1,2,3-thiadiazol-2-yl] phenol (16). After TLC justification and recrystallization, the orange-yellow crystals were solid and steady in both air and water. The compound was not soluble in water but in many polar organic solvents. The method was cost-effective, quick, and provided high yields (82%), with the new compound characterized by CHNS elemental analyzers, FT-IR, 1H-NMR, and 13C-NMR spectroscopic analysis.
Using DMSO–d6 as a solvent, the 13C-NMR spectra for the newly produced compounds was obtained at 125MHz. The spectrum showed signal at 116.31 ppm that may be attributed to the aromatic (C10, C12, C10’, C12’), and a signal at 128.87 ppm may be assigned to aromatic (C8, C8’, C9’, C13’), while the signal at 132.58 ppm may be attributed to aromatic (C9, C13), signal at 163.82 ppm may be due to (C7, C11, C11’) in which these carbon atoms attached directly to electronegative atoms, i.e., two hydroxyl groups (C11, C11’) and nitrogen and phenyl group in (C7), signal at 173.12 ppm may be assigned to aromatic (C2) within the heterocyclic ring, another signal at 191.44 ppm according to the aromatic carbon atoms attached directly to nitrogen and Sulphur atoms (C5) within heterocyclic ring and another nitrogen atom of imine group. All the spectroscopic analysis as shown above confirm the propose structure of the new synthesized compound.
Microwave synthesis offers numerous advantages, including excellent yield under mild circumstances and shorter durations (26). In general, Schiff bases have exhibited a wide spectrum of biological action (27), including anti-proliferative, antimalarial (28), analgesic, anti-inflammatory (29), antiviral, antifungal, antipyretic (30), and antibacterial properties (16).
Due to their biological properties, the azomethine or imine group (>C=N-) appears very important. Due to rising bacterial infection mortality and the rise of multidrug-resistant strains, more efficient antibacterial medication is needed (31).
The activity against bacteria was significantly affected by minor structural modifications, as discovered before (32). The unique functional group arrangement in Schiff-bases may not interact well with E. coli cell structure, as the bacteria can develop resistance mechanisms to antibacterial drugs due to efflux pumps, altered membrane permeability, and enzymatic chemical breakdown. If a Schiff-base molecule is sensitive to these resistance mechanisms, it may not effectively inhibit E. coli growth (33). Schiff-bases may aim at certain compounds found in bacterial cells. If these targets are not available in E. coli, the chemical may not have significant antibacterial effect against this strain (34). This may be attributed to the compound structure and virulence factor of the bacteria (35). Examined Schiff-base targets bacterial cells, highlighting the importance of antibiotic chemicals ability to penetrate cell walls and reach the intracellular targets. Some Schiff-base compounds may have reduced entry capacity, reducing antibacterial effectiveness (36). The antibacterial properties of phenol and thiadiazol compounds vary according to their derivatives, structure, and bacterial target. It can attach to the bacterial cell walls and increase their permeability, which causes critical ions and biomolecules to escape out and cause cell lysis (37). It can also interact with bacterial DNA (38), inhibit bacterial enzymes (31), or stop the production of biofilms (39).
Research reveals that antibacterial medicines face challenges in piercing cells as the antibacterial activity of Schiff-bases are influenced by pH levels and E. coli lives in different pH settings. This affects their antibacterial efficiency. Schiff-base compounds have shown antibacterial activity against certain strains like E. coli. However, their lack of activity in some cases suggests the need to consider factors like chemical structure, bacterial resistance mechanisms, target specificity, intracellular penetration, and pH sensitivity. This investigation also demonstrated the highest activity of the new Schiff-base phenol chemical against prostate cancer cells at 72 hr, thus the longer exposure time highlights greater effect, as a representative for human cancer cell lines, as compared to previous studies indicating its high cytotoxicity against cancer cells (35, 36).
Similar studied revealed synthesis and obtaining favorable antibacterial and anticancer activities from thiadiazol compound (40). Despite the fact that antibiotic-resistant microorganisms reduce antibiotics effectiveness, antibiotics are still regarded as one of the most effective medical treatments (41) and the compound showed results similar to our study.
The investigated compound showed strong activity against different Gram-positive and Gram-negative bacterial strains. In comparison with commonly used antibiotics, it can be used as alternative formula. This compound is novel and needs further investigation to be suggested as drug in the future.
The synthesis of new natural compounds using cost-effective and quick methods such as microwave method is very important to control the resistant diseases. Our synthesized compound showed appropriate antibacterial and anticancer activities.
FT-IR: Fourier transform infrared spectroscopy
1H-NMR: Proton nuclear magnetic resonance
13C-NMR: Carbon-13 nuclear magnetic resonance
CHNS: CHNS elemental analyzers
TLC: Thin Layer Chromatography
DMSO: Dimethyl sulfoxide.
The authors acknowledge the College of Pharmacy, University of Basrah for providing lab facility.
Ethical Considerations
The ethical approval was obtained from the Institutional Review Board Committee of Al-Zahraa college of Medicine/ University of Basrah/ Basrah-Iraq. Number: E/T/44, Date 3/01/2024.
Authors’ Contributions
All authors participated in gathering the data and review of the manuscript. All authors have reviewed the manuscript and given their approval for publication.
Conflicts of Interest
This research received no specific grant from any funding agency in the public, commercial, or not for profit sector.
The authors were not utilized AI Tools.
Received: 2025/01/9 | Accepted: 2025/03/1 | ePublished: 2025/03/30
| Rights and permissions | |
 |
This work is licensed under a Creative Commons Attribution-NonCommercial 4.0 International License. |